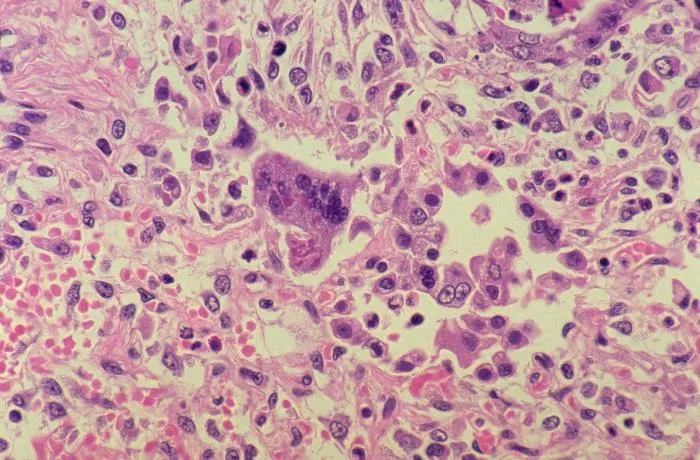
Stara plaga - Odra może powrócić. Preparat przedstawia Morbillivirus

Przeciążenie nadgarstka na WF – zespół Sudecka na przyczajce
To nie była scena z medycznego tasiemca, tylko zwykły wtorek na sali gimnastycznej. Dwunastoletnia dziewczynka, błahe „przeciążenie” nadgarstka – coś, co u większości dzieciaków kończy się altacetem i tygodniem marudzenia. A jednak, biologia bywa złośliwą bestią i czasem postanawia urządzić w organizmie prawdziwe „widowisko”, na które nikt nie kupował biletów. Zaczęło się od niewinnego obrzęku, […]
Przeciążenie nadgarstka na WF – zespół Sudecka na przyczajce Dowiedz się więcej »